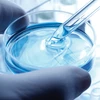
Lab testing

Neogen stock surges 9% in weak market on strong Q3; soars 28% in 5 days
The management is confident of achieving FY26 revenue guidance of Rs 950-1,000 crore in the standalone business; beyond FY26, the rapid scale up in Neogen Ionics will drive consolidated performance
SI Reporter Mumbai Shares of Neogen Chemicals surged 9 per cent to Rs 2,160 on the BSE in Monday’s intra-day trade after the company delivered a healthy performance in the December quarter (Q3FY25), with profit after tax (PAT) rising 844 per cent year-on-year (YoY) to Rs 10 crore.
The company said the robust PAT growth was achieved through a combination of solid operating performance and a favorable base effect resulting from one-time expenses recognised in Q3 of the prior year.
At 01:07 PM, Neogen was trading 5 per cent higher at Rs 2,083.55 on the BSE, as compared to the 0.45 per cent decline in the BSE Sensex. In the past five trading days, the stock price of the smallcap specialty chemicals company has soared 28 per cent.
In Q3FY25, the company's revenue was higher by 22 per cent YoY, at Rs 201 crore, boosted by volume growth in the base business and a healthy contribution from BuLi Chem, which is now a part of Neogen Chemicals standalone. This was despite lower Bromine prices. New product launches and the pursuit of export opportunities drove the robust recovery.
The company said the battery chemicals arm (Neogen Ionics) has commenced lithium salt exports, contributing to the topline. Neogen Ionics is positioned for substantial growth from the next financial year driven by new capacities.
The company’s earnings before interest, tax, depreciation and amortisation (Ebitda) grew 71 per cent YoY to Rs 34.6 crore, and Ebitda margins stood at 17.2 per cent (up 485 bps) due to a 100-bps gross profit margin improvement, increased plant utilisation, operational efficiencies, and lower employee costs.
Meanwhile, on an overall basis, the management is confident of achieving FY26 revenue guidance of Rs 950-1,000 crore in the standalone business. Beyond FY26, the rapid scale up in Neogen Ionics will drive consolidated performance. The management maintains a long-term growth strategy, undeterred by short-term setbacks. Neogen Chemicals remains committed to capitalising on emerging opportunities to generate sustained value for all stakeholders, the management said.
Beyond results, the focus is on the capex the company has initiated for battery chemicals. It plans to manufacture Lithium-ion battery electrolyte salts and electrolytes with a total capital outlay of Rs 1,450-Rs 1,500 crore to be incurred over the course of FY2024 to FY2026. The funding will be via 70-75 per cent of debt. The plan is to build optimum capacities for 32,000 MTPA of electrolytes and 5,500 MTPA of electrolyte salts, with peak revenue potential for the capacity addition ranging from Rs 2,500 to Rs 2,950 crore, depending on lithium prices, ICICI Securities said in a note.
)

